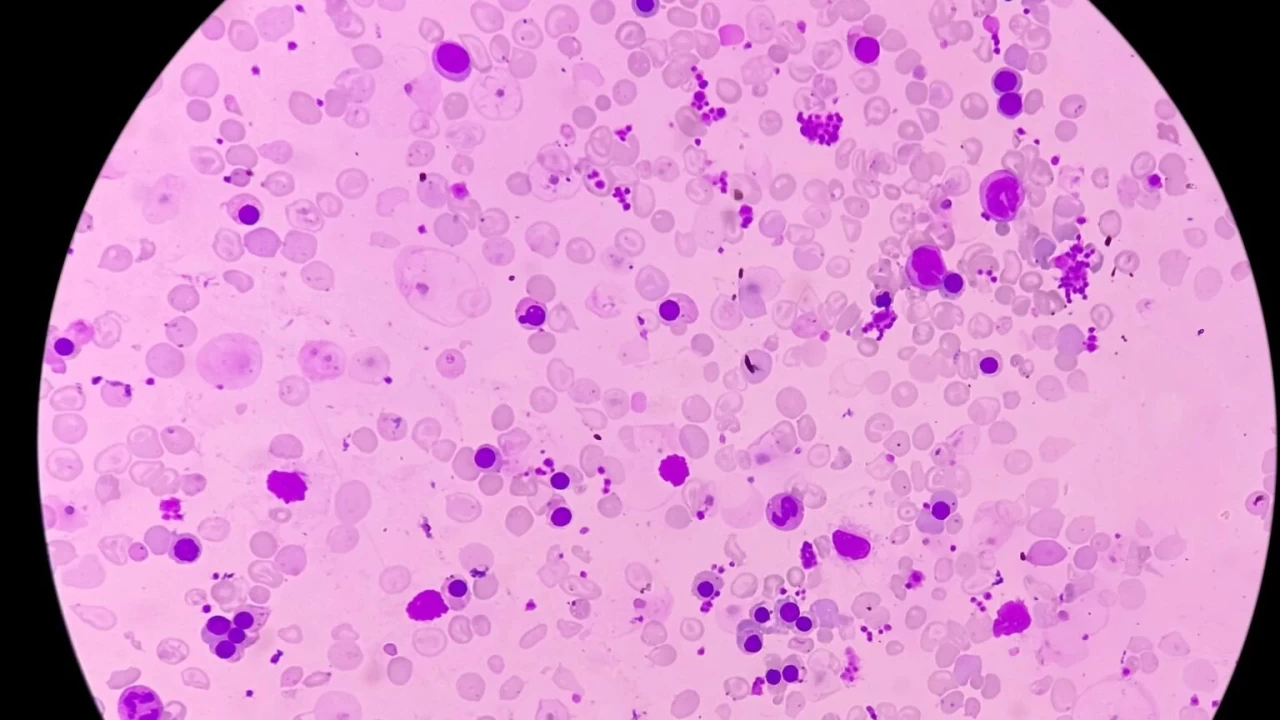

NRBC kan analizi ile dolaşımda bulunan çekirdek içeren kırmızı kan hücrelerinin (NRBC) miktarı belirlenmektedir. Yapılan test sonucunda NRBC değeri 0.01-0.10 aralığında ise bu durum NRBC eksikliği olarak değerlendirilir. Sağlıklı bireylerde NRBC testi sonucu 0 olmalıdır. NRBC seviyesinin düşmesinin en yaygın sebepleri şunlardır.
Kan Tahlilinde Nrbc Ne Demek?
SelfDecode Labs’ta NRBC nedir? sorusuna verilen yanıt şu şekildedir: “NRBC, tam olarak gelişmemiş kırmızı kan hücreleri anlamına gelir. Yetişkin bireylerde kanda NRBC tespit edilmesi, bir sağlık problemine işaret edebilir.”
Uzmandoktor.net’te NRBC düşüklüğü nedenleri şu şekilde belirtilmiştir:
Vücutta enfeksiyon bulunması
Akdeniz anemisi
Kanla ilgili hastalıklar
Fiziksel stres
Karaciğer hastalıkları
Kemik iliği stresine bağlı durumlar (kök hücre hastalıkları)
Yüksek irtifada bulunmak
Uyku apnesi
Karbon monoksit zehirlenmesi
Nöroblastom (gelişmemiş sinir hücrelerinin kanseri)
Gaucher hastalığı (organlarda yağ birikmesi)
Tüberküloz
Diyabetik ketoasidoz
Enflamatuar bağırsak hastalıkları
Böbrek nakli
Kolajen vasküler hastalık (doku hastalığı)
Mantar enfeksiyonları
Çevresel toksinler, kirletici maddeler veya kimyasallar
Hareket eksikliği
Düzensiz beslenme
Uyku eksikliği veya aşırı uyku
Sarkoidoz (sistemik hastalıklar)
Myelofthisis (şiddetli anemi)
Miyeloid metaplazi (ilerleyici kemik iliği skarlaşması)
Kronik hemolitik anemi
Polisitemi vera (aşırı kırmızı kan hücresi üretimi)
Lösemi (kan kanseri)
Üremi (kanda üre yüksekliği)
Sepsis (şiddetli enfeksiyon reaksiyonu)
Yanıklar
Kemoterapinin yan etkileri
Kurşun zehirlenmesi
Hamilelik